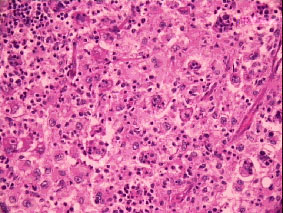
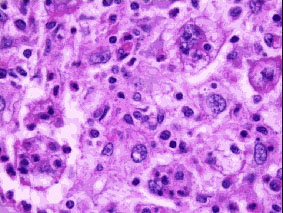

Una
strana linfoadenopatia laterocervicale
Pediatria
- Ospedale Fatebenefratelli - Benevento
*
Chirurgia Generale - Ospedale Bambino Gesù - Roma
**
Anatomia Patologica - Ospedale Bambino Gesù - Roma
Cervical
lymphadenopathy: Rosai-Dorfman disease
Keywords:Lymphadenopathy,
Rosai-Dorfman disease
Summary
Case
report of cervical lymphaadenopathy appeared 15 days after auricular
piercing followed by local inflammation; hystological finding of
sinus histiocytosis with lymphocyte-emophagocytosis.
Descrizione
del caso
G.G.
nata il 02.09.99, abita in campagna.
Parto
eutocico, dopo gravidanza normodecorsa, peso alla nascita di gr 3620,
assenza di problemi perineonatali.
Anamnesi
familiare negativa per particolari patologie. Latte materno fino
all'osservazione, svezzamento a 4 mesi. Bronchiolite all'età
di 2 mesi. Crescita regolare, normale sviluppo psico-neuromotorio.
All'età
di 7 mesi e 1/2 comparsa di tumefazione in regione laterocervicale
destra della grandezza di una noce senza altra sintomatologia. Dopo 4
giorni compare anche a sinistra analoga tumefazione.
Condotta
a visita, il pediatra curante non riscontrando altri segni tranne la
linfoadenomegalia laterocervicale bilaterale, richiede indagini di
laboratorio.
Emocromo
normale tranne neutrofilia relativa (GB 10800, N 64%), VES 130 mm/Ih,
PCR 1.9 mcg/dl.
Nella
norma: profilo epatico, renale, sierologia per Widal-Wright, TORCH,
EBV, tampone faringeo.
A
10 giorni dall'inizio della patologia, data la persistenza della
sintomatologia con restante obiettività negativa, il pediatra
prescrive terapia con cefaclor, ma dopo 3 giorni data l'assenza di
risultati apprezzabili, invia la piccola a ricovero presso di noi.
Ricovero
ospedaliero:
sono
ormai trascorsi 14 giorni dall'inizio dei sintomi e clinicamente
l'unico dato apprezzabile è l'ipertrofia delle stazioni
linfonodali laterocervicali (3x2 cm a sn, 3x3 cm a dx). La cute
sovrastante è rosea, non calda al termotatto, non vi è
aderenza ai piani superficiali e profondi, vi è dolorabilità
alla palpazione, la consistenza è dura elastica. La piccola è
apirettica, le restanti stazioni linfonodali sono normali come pure
gli organi ipocondriaci.
Richiediamo
varie indagini:
emocromo:
GB 12.200 (N 58, L 27, M 11, E 2.5, B 0.3), GR 4.020.000, Hb 9.7, Ht
28.8, MCV 71.5, Plt 506.000.
VES 60
mm/Ih, PCR 2.18 mcg/dl, sideremia 26 mcg%ml, lieve aumento della alfa
2 al protidogramma.
Nella
norma: azotemia, glicemia, TAS, ferritinemia, QPE, transaminasi, LDH,
Ig sieriche, TORCH, sierologia per EBV e per B. Henselae, es. urine ,
Tine test, Rx torace
Ecografia
del collo: nella regione laterocervicale si osserva bilateralmente la
presenza di numerosi linfonodi di dimensioni variabili dai 28 mm ai
12 mm, raggruppati a pacchetto. Tutti presentano architettura
parenchimale conservata senza rilievo di aree colliquative.
Ipotesi
diagnostiche: linfoadenite batterica, reattiva, sistemica.
Da
un supplemento anamnestico circa 15 giorni prima della comparsa della
sintomatologia, a G. erano stati praticati due fori ai lobi delle
orecchie per applicare degli orecchini. Dopo qualche ora la piccola
aveva cominciato a piangere con insistenza e, contemporaneamente, era
comparsa una reazione infiammatoria importante ai lobi. Dopo circa 24
ore aveva inizio una febbre piuttosto elevata (39°C) e sui lobi
compariva secrezione purulenta. Di conseguenza la madre, dopo aver
tolto gli orecchini, medicava la piccola con acqua ossigenata ed
alcool somministrando per la febbre paracetamolo.
L'evento
apparentemente si risolveva nel giro di 48 ore, senza altro
intervento terapeutico. Tuttavia a distanza di quattro giorni, la
madre notava una piccola tumefazione alla destra del collo, che dopo
altri tre giorni aumentava considerevolmente di volume divenendo
anche bilaterale.
Di
conseguenza abbiamo ritenuto possibile un coinvolgimento batterico
bilaterale dei linfonodi laterocervicali secondario alla infezione
dei lobi auricolari. Inoltre la terapia con cefaclor (5 giorni)
apparentemente aveva determinato una riduzione delle tumefazioni.
Pertanto abbiamo dimesso la piccola con il consiglio di continuare la
terapia antibiotica per altri 9 giorni e poi tornare a controllo.
Seconda
osservazione:
la
situazione clinica era invariata, anzi le tumefazioni apparivano
addirittura aumentate di volume.
La
genesi batterica della patologia era ritenuta poco attendibile per
cui dopo una discussione del caso si è deciso che, per una
definizione diagnostica, era necessaria una biopsia linfonodale.
Invio
a ricovero all'Ospedale Bambino Gesù di Roma:
veniva
eseguito un aspirato midollare che rileveva un midollo ricco, con
lieve iperplasia granulopoietica e con eosinofilia; apparentemente
normali la serie eritroblastica e megacariocitica.
L'ecografia
del collo mostrava la presenza di tumefazioni linfonodali con
ecostruttura lievemente disomogenea e assenza dell'eco del seno
centrale ed ipertrofia del centro germinativo rispetto alla
corticale.
L'intervento
chirurgico per biopsia a destra evidenziava al disotto del muscolo
sternocleidomastoideo di destro la presenza di una voluminosa
tumefazione biancastra costituita da più linfonodi
apparentemente separati di consistenza duro-lignea.
All'esame
istologico: istiocitosi massiva dei seni con linfoadenopatia o
malattia di Rosai-Dorfman.

Fig.1
(Istologico da biopsia linfonodale)
Fig.2
(osservazione a maggior ingrandimento)
Fig.3
(ulteriore ingrandimento ove si osserva la linfocitofagocitosi o
emperipolesi caratteristica peculiare della malattia di
Rosai-Dorfman)
G.
successivamente praticava TAC encefalica e Rx-total body, che tranne
la presenza di numerosi linfonodi aumentati di volume al collo,
aumentati di volume bilateralmente, soprattutto a destra e nello
spazio retrofaringeo e in sede sopraclaveare dx, non ha mostrava
alterazioni particolari degli apparati ed organi esaminati.
La
Rxgrafia dello scheletro in toto non evidenziava lesioni
osteolitiche.
ROSAI-DORFMAN
DESEASE
1.
GENERAL INFORMATION
1.1
Epidemiological data
Rosai-Dorfman
disease most commonly affects adults, with a peak age around 20
years.
It is a
world-wide sporadic disease, with occasional clusters, which suggest
either an infective precipitant or genetic clusters.
1.2
Etiologic and risk factors
Etiology
is unknown. The lesional cell derivation from circulating mononuclear
cells suggests a reactive disorder.
2.
PATHOLOGY and BIOLOGY
2.1
Biological data
The
affected cells are activated macrophages
2.2
Histopathology
Histiocytes
with abundant pale cytoplasm and round to oval nuclei and a single
nucleolus massively engorge sinuses and interfollicular areas of
lymphnodes, usually with evidence of lymphocytophagocytosis.
3.
DIAGNOSIS
3.1 Signs
and symptoms
Massive
bilateral painless cervical and paratracheal lymphadenopathy is the
presenting symptom in the vast majority (90% of cases). Inguinal and
axillary lymphadenopathies are less common (20% of patients). Other
sites of lymphadenopathic involvement include mediastinum and upper
para-aortic nodes (10-15%), The most common sites of extranodular
involvement are the skin, upper respiratory tract and Waldeyer's
area, and bone. Systemic symptoms are rare. Bone marrow, liver and
spleen are usually spared.
3.2
Diagnostic strategy
Lymph
node biopsy is the basis for the diagnosis of Rosai-Dorfman disease.
4.
PROGNOSIS
4.1
Natural history
The
clinical course can be indolent for many years, with spontaneous
regression in the majority of patients and complete resolution in
approximately 20% of patients, even after a long time. It does not
usually threaten life or organ function. In a minority of patients
the disease may become progressive and require treatment. Only
anecdotal deaths due to the disease and associated complications have
been reported.
4.2
Prognostic factors
Involvement
of certain extranodal organs such as kidneys and lungs or widespread
nodal dissemination are considered poor prognostic factors.
5.
TREATMENT
5.1
Treatment of asymptomatic disease
Most
patients with Rosai-Dorfman disease are asymptomatic and an initial
wait-and-see approach is a standard option, since spontaneous
regression may occur and treatment is often unsuccessful.
5.2
Treatment of symptomatic disease
For
patients with progressive or symptomatic presentation or for those
requiring treatment because of cosmetic problems, standard treatment
is corticosteroid therapy, usually prednisone at high doses (2 mg/kg
daily for at least one month).
Bibliografia
Rosai J ,
Dorfman RF : Sinus histiocytosis with massive lymphadenopathy, a
newly recognized benign clinopathological entity. Arch Pathol Lab Med
1969; 87:63-70
Rosai J ,
Dorfman RF : Sinus histiocytosis with massive lymphadenopathy, a
pseudolymphomatous benign disorder. Analysis of 34 cases. Cancer
1972; 30: 1174-88
Foucar E,
Rosai J, Dorfman RF: Sinus histiocytosis with massive lymphadenopathy
(Rosai-Dorfman disease). Review of the entity. Semin Diagn Pathol
1990; 7: 19-73
Pettinato
G, Manivel JC et al. : Fine needle aspiration cytology and
immunocytochemical characterization of the histiocytes in sinus
histiocytosis with massive lymphadenopathy ( Rosai-Dorfman syndrome).
Acta Cytol 1990 Nov-Dec; 34 (6): 771-7
Horneff
G, Jurgens H, Hort W, Karitzky D, Gobel U: Sinus histiocytosis with
massive lymphadenopathy (Rosai-Dorfman disease): respense to
methotrexate and mercaptopurine. Med Pediatr Oncol 1996, Sep; 27(3):
187-92.
Das DK,
Gulati A , Bhatt NC, Sethi GR: Sinus histhiocytosis with massive
lymphadenopathy (Rosai-Dorfman disease): report of two cases with
fine-needle aspiration cytology. Diagn Cytopathol 2001 Jan; 24(1):
42-5.
